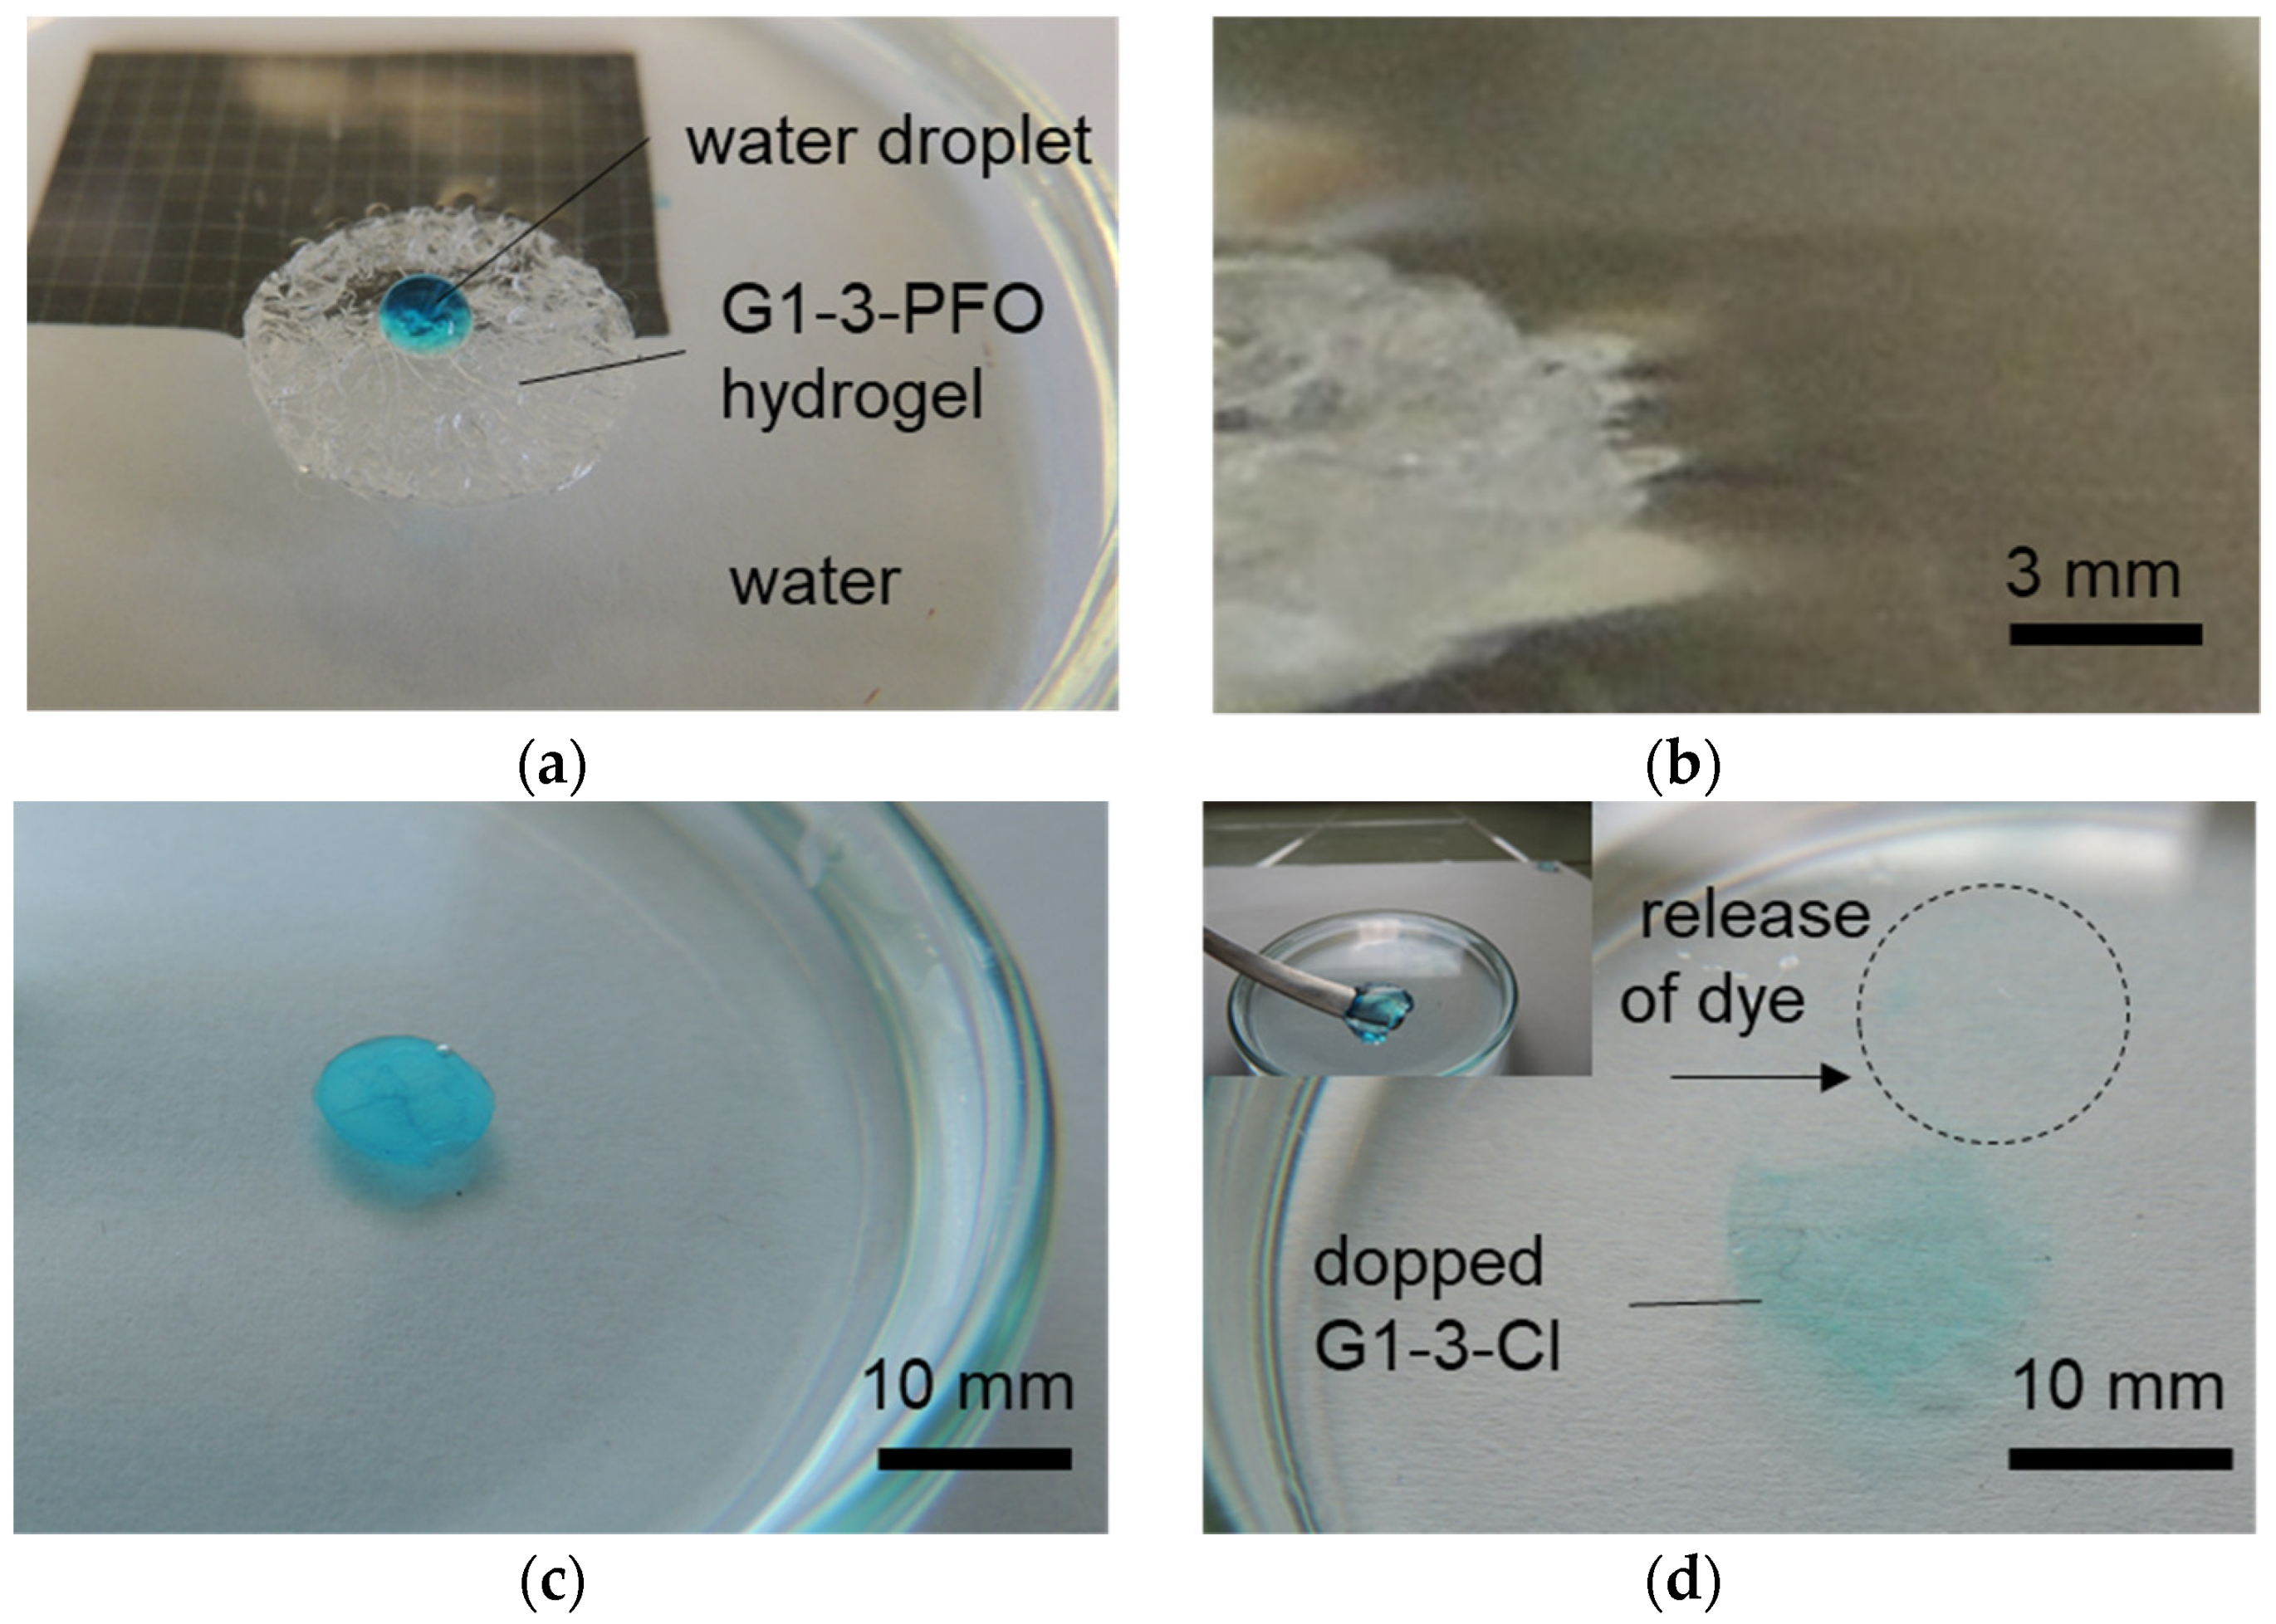
Gels 07 00109 g006 550

Exchange Counterion in Polycationic Hydrogels: Tunability of Hydrophobicity, Water State, and Floating Capability for a Floating pH Device
Abstract
:1. Introduction
2. Results and Discussion
2.1. Hydrogel Formation and Its Characterization
2.2. Counterion Exchange Study
2.3. Water State in the Hydrogels
2.4. Wettability of the Hydrogels
2.5. Water Characteristics, Morphology, and Polarity Study
2.6. Floating Capability of the PFO-Based Gel and Its Application as a Microdevice for pH Detection
3. Conclusions
4. Materials and Methods
4.1. Materials
4.2. Hydrogel Preparation
4.3. Anion Exchange
4.4. Methods
Supplementary Materials
Author Contributions
Funding
Institutional Review Board Statement
Informed Consent Statement
Conflicts of Interest
References
- Stuart, M.A.C.; Huck, W.T.S.; Genzer, J.; Müller, M.; Ober, C.; Stamm, M.; Sukhorukov, G.B.; Szleifer, I.; Tsukruk, V.V.; Urban, M.; et al. Emerging Applications of Stimuli-Responsive Polymer Materials. Nat. Mater. 2010, 9, 101–113. [Google Scholar] [CrossRef]
- Yuk, H.; Lu, B.; Zhao, X. Hydrogel Bioelectronics. Chem. Soc. Rev. 2019, 48, 1642–1667. [Google Scholar] [CrossRef] [PubMed] [Green Version]
- Veld, R.C.; van den Boomen, O.I.; Lundvig, D.M.S.; Bronkhorst, E.M.; Kouwer, P.H.J.; Jansen, J.A.; Middelkoop, E.; Von den Hoff, J.W.; Rowan, A.E.; Wagener, F.A.D.T.G. Thermosensitive Biomimetic Polyisocyanopeptide Hydrogels may Facilitate Wound Repair. Biomaterials 2018, 181, 392–401. [Google Scholar] [CrossRef] [PubMed]
- Brighenti, R.; Li, Z.; Vernerey, F.J. Smart Polymers for Advanced Applications: A Mechanical Perspective Review. Front. Mater. 2020, 7, 196. [Google Scholar] [CrossRef]
- Chaterji, S.; Kwon, I.K.; Park, K. Smart Polymeric Gels: Redefining the Limits of Biomedical Devices. Prog. Polym. Sci. 2007, 32, 1083–1122. [Google Scholar] [CrossRef] [Green Version]
- Zhang, Y.S.; Khademhosseini, A. Advances in Engineering Hydrogels. Science 2017, 356, eaaf3627. [Google Scholar] [CrossRef]
- Ping, Y.H.; Nguyen, Q.T.; Chen, S.M.; Zhoua, J.Q.; Ding, Y.D. States of Water in Different Hydrophilic Polymers—DSC and FTIR Studies. Polymer 2001, 42, 8461–8467. [Google Scholar] [CrossRef]
- Rosales, A.M.; Anseth, K.S. The Design of Reversible Hydrogels to Capture Extracellular Matrix Dynamics. Nat. Rev. Mater. 2016, 1, 15012. [Google Scholar] [CrossRef] [Green Version]
- Halperin, A.; Kröger, M.; Winnik, F.M. Poly(N-Isopropylacrylamide) Phase Diagrams: Fifty Years of Research. Angew. Chem. Int. Ed. 2015, 54, 15342–15367. [Google Scholar] [CrossRef]
- Lanzalaco, S.; Armelin, E. Poly(N-Isopropylacrylamide) and Copolymers: A Review on Recent Progresses in Biomedical Applications. Gels 2017, 3, 36. [Google Scholar] [CrossRef]
- Ilcikova, M.; Tkac, J.; Kasak, P. Switchable Materials Containing Polyzwitterion Moieties. Polymers 2015, 7, 2344–2370. [Google Scholar] [CrossRef]
- Jochum, F.D.; Theato, P. Temperature- and Light-Responsive Smart Polymer Materials. Chem. Soc. Rev. 2013, 42, 7468–7483. [Google Scholar] [CrossRef] [PubMed]
- Kasak, P.; Sasová, J.; Shoheeduzzaman, R.; Baig, M.T.; Alyafei, A.A.H.A.; Tkac, J. Influence of Direct Electric Field on PMCG-Alginate-Based Microcapsule. Emergent Mater. 2021, 4, 769–779. [Google Scholar] [CrossRef]
- Han, D.; Farino, C.; Yang, C.; Scott, T.; Browe, D.; Choi, W.; Freeman, J.W.; Lee, H. Soft Robotic Manipulation and Locomotion with a 3D Printed Electroactive Hydrogel. ACS Appl. Mater. Interfaces 2018, 10, 17512–17518. [Google Scholar] [CrossRef]
- Reyes-Ortega, F. pH-Responsive Polymers: Properties, Synthesis and Applications. In Smart Polymers and Their Applications; Aguilar, M.R., Román, J.S., Eds.; Woodhead Publishing: Cambridge, UK, 2014; Chapter 3; pp. 45–92. [Google Scholar] [CrossRef]
- Jaeger, W.; Bohrisch, J.; Laschewsky, A. Synthetic Polymers with Quaternary Nitrogen Atoms-Synthesis and Structure of the most used Type of Cationic Polyelectrolytes. Prog. Polym. Sci. 2010, 35, 511–577. [Google Scholar] [CrossRef]
- Osicka, J.; Ilcikova, M.; Popelka, A.; Filip, J.; Bertok, T.; Tkac, J.; Kasak, P. Simple, Reversible and Fast Modulation in Superwettability, Gradient and Adsorption by Counterion Exchange on Self-Assembled Monolayer. Langmuir 2016, 32, 5491–5499. [Google Scholar] [CrossRef] [PubMed]
- Mosnacek, J.; Popelka, A.; Osicka, J.; Filip, J.; Ilcikova, M.; Kollar, J.; Yousaf, A.B.; Bertok, T.; Tkac, J.; Kasak, P. Modulation of Wettability, Gradient and Adhesion on Self-Assembled Monolayer by Counterion Exchange and pH. J. Colloid Interface Sci. 2018, 512, 511–521. [Google Scholar] [CrossRef]
- Zhang, G.; Zhang, X.; Li, M.; Su, Z. A Surface With Superoleophilic-To-Superoleophobic Wettability Gradient. ACS Appl. Mater. Interfaces 2014, 6, 1729–1733. [Google Scholar] [CrossRef]
- Zhang, G.; Zhang, X.; Huang, Y.; Su, Z. A Surface Exhibiting Superoleophobicity Both in Air and in Seawater. ACS Appl. Mater. Interfaces 2013, 5, 6400–6403. [Google Scholar] [CrossRef]
- Wang, L.; Peng, B.; Su, Z. Tunable Wettability and Rewritable Wettability Gradient from Superhydrophilicity to Superhydrophobicity. Langmuir 2010, 26, 12203–12208. [Google Scholar] [CrossRef]
- Yang, J.; Zhang, Z.; Men, X.; Xu, X.; Zhu, X.; Zhou, X.; Xue, Q. Rapid and Reversible Switching between Superoleophobicity and Superoleophilicity in Response to Counterion Exchange. J. Colloid Interface Sci. 2012, 366, 191–195. [Google Scholar] [CrossRef]
- Wang, L.; Lin, Y.; Peng, B.; Su, Z. Tunable Wettability by Counterion Exchange at the Surface of Electrostatic Self-Assembled Multilayers. Chem. Commun. 2008, 45, 5972–5974. [Google Scholar] [CrossRef] [PubMed]
- Xu, L.; Chen, W.; Mulchandani, A.; Yan, Y. Reversible Conversion of Conducting Polymer Films from Superhydrophobic to Superhydrophilic. Angew. Chem. Int. Ed. 2005, 44, 6009–6012. [Google Scholar] [CrossRef] [PubMed]
- Park, M.; Lee, J.; Lee, B.; Lee, Y.; Choi, I.; Lee, S. Covalent Modification of Multiwalled Carbon Nanotubes with Imidazolium-Based Ionic Liquids: Effect of Anions on Solubility. Chem. Mater. 2006, 18, 1546–1551. [Google Scholar] [CrossRef]
- Azzaroni, O.; Brown, A.; Huck, W. Tunable Wettability by Clicking Counterions into Polyelectrolyte Brushes. Adv. Mater. 2007, 19, 151–154. [Google Scholar] [CrossRef]
- Huang, C.; Chen, Y.; Chang, Y. Counterion-Activated Nanoactuator: Reversibly Switchable Killing/Releasing Bacteria on Polycation Brushes. ACS Appl. Mater. Interfaces 2015, 7, 2415–2423. [Google Scholar] [CrossRef]
- Hua, Z.; Yang, J.; Wang, T.; Liu, G.; Zhang, G. Transparent Surface with Reversibly Switchable Wettability between Superhydrophobicity and Superhydrophilicity. Langmuir 2013, 29, 10307–10312. [Google Scholar] [CrossRef]
- Moya, S.; Azzaroni, O.; Farhan, T.; Osborne, V.; Huck, W. Locking and Unlocking of Polyelectrolyte Brushes: Toward the Fabrication of Chemically Controlled Nanoactuators. Angew. Chem. Int. Ed. 2005, 44, 4578–4581. [Google Scholar] [CrossRef]
- Kwon, H.; Osada, Y.; Gong, J. Polyelectrolyte Gels-Fundamentals and Applications. Polym. J. 2006, 38, 1211–1219. [Google Scholar] [CrossRef] [Green Version]
- Rumyantsev, A.M.; Pan, A.; Roy, S.G.; De, P.; Kramarenko, E.Y. Polyelectrolyte Gel Swelling and Conductivity vs Counterion Type, Cross-Linking Density, and Solvent Polarity. Macromolecules 2016, 49, 6630–6643. [Google Scholar] [CrossRef]
- He, Y.; Wu, C.; Hua, M.; Wu, S.; Wu, D.; Zhu, X.; Wang, J.; He, X. Bioinspired Multifunctional Anti-Icing Hydrogel. Matter 2020, 2, 723–734. [Google Scholar] [CrossRef] [Green Version]
- Xu, X.; Jerca, V.V.; Hoogenboom, R. Bio-Inspired Hydrogels as Multi-Task Anti-Icing Hydrogel Coatings. Chem 2020, 6, 820–822. [Google Scholar] [CrossRef] [Green Version]
- Wrede, M.; Ganza, V.; Bucher, J.; Straub, B.F. Polyelectrolyte Gels Comprising a Lipophilic, Cost-Effective Aluminate as Fluorine-Free Absorbents for Chlorinated Hydrocarbons and Diesel Fuel. ACS Appl. Mater. Interfaces 2012, 4, 3453–3458. [Google Scholar] [CrossRef]
- Ono, T.; Sugimoto, T.; Shinkai, S.; Sada, K. Lipophilic Polyelectrolyte Gels as Super-Absorbent Polymers for Nonpolar Organic Solvents. Nat. Mater. 2007, 6, 429–433. [Google Scholar] [CrossRef] [PubMed]
- Sada, K. Lipophilic Polyelectrolyte Gels and Crystal Crosslinking, New Methods for Supramolecular Control of Swelling and Collapsing of Polymer Gels. Bull. Chem. Soc. Jpn. 2018, 91, 1282–1292. [Google Scholar] [CrossRef] [Green Version]
- Pourjavadi, A.; Doulabi, M.; Hosseini, S.H. Novel Polyelectrolyte Gels as Absorbent Polymers for Nonpolar Organic Solvents based on Polymerizable Ionic Liquids. Polymer 2012, 53, 5737–5742. [Google Scholar] [CrossRef]
- Guo, H.; Nakajima, T.; Hourdet, D.; Marcellan, A.; Creton, C.; Hong, W.; Kurokawa, T.; Gong, J.P. Hydrophobic Hydrogels with Fruit-Like Structure and Functions. Adv. Mater. 2019, 31, 1900702. [Google Scholar] [CrossRef]
- Oliveira, N.M.; Zhang, Y.S.; Ju, J.; Chen, A.; Chen, Y.; Sonkusale, S.R.; Dokmeci, M.R.; Reis, R.L.; Mano, J.F.; Khademhosseini, A. Hydrophobic Hydrogels: Toward Construction of Floating (Bio)microdevices. Chem. Mater. 2016, 28, 3641–3648. [Google Scholar] [CrossRef]
- Zhao, C.; Zheng, J. Synthesis and Characterization of Poly(N-Hydroxyethylacrylamide) for Long-Term Antifouling Ability. Biomacromolecules 2011, 12, 4071–4079. [Google Scholar] [CrossRef]
- Zhao, C.; Patel, K.; Aichinger, L.M.; Liu, Y.; Hu, R.; Chen, H.; Li, X.; Li, L.; Zhang, G.; Chang, Y.; et al. Antifouling and Biodegradable Poly(N-Hydroxyethylacrylamide) (polyHEAA)-based Nanogels. RSC Adv. 2013, 3, 19991–20000. [Google Scholar] [CrossRef]
- Danko, M.; Kroneková, Z.; Mrlik, M.; Osicka, J.; bin Yousaf, A.; Mihálová, A.; Tkac, J.; Kasak, P. Sulfobetaines Meet Carboxybetaines: Modulation of Thermo- and Ion-Responsivity, Water Structure, Mechanical Properties, and Cell Adhesion. Langmuir 2019, 35, 1391–1403. [Google Scholar] [CrossRef] [PubMed]
- Ye, L.; Zhang, Y.; Wang, Q.; Zhou, X.; Yang, B.; Ji, F.; Dong, D.; Gao, L.; Cui, Y.; Yao, F. Physical Cross-Linking Starch-Based Zwitterionic Hydrogel Exhibiting Excellent Biocompatibility, Protein Resistance, and Biodegradability. ACS Appl. Mater. Interfaces 2016, 8, 15710–15723. [Google Scholar] [CrossRef] [PubMed]
- Zhang, Z.; Chao, T.; Shaoyi, J. Physical, Chemical, and Chemical−Physical Double Network of Zwitterionic Hydrogels. J. Phys. Chem. B 2008, 112, 5327–5332. [Google Scholar] [CrossRef]
- Norioka, C.; Inamoto, Y.; Hajime, C.; Kawamura, A.; Miyata, T. A Universal Method to Easily Design Tough and Stretchable Hydrogels. NPG Asia Mater. 2021, 13, 34. [Google Scholar] [CrossRef]
- Okhapkin, I.M.; Makhaeva, E.E.; Khokhlov, A.R. Water Solutions of Amphiphilic Polymers: Nanostructure Formation and Possibilities for Catalysis. In Conformation-Dependent Design of Sequences in Copolymers I, Advances in Polymer Science; Khokhlov, A.R., Ed.; Springer: Berlin, Germany, 2006; Volume 195, pp. 177–210. [Google Scholar] [CrossRef]
- Kasák, P.; Mosnáček, J.; Danko, M.; Krupa, I.; Hloušková, G.; Chorvát, D.; Koukaki, M.; Karamanou, S.; Economoude, A.; Lacík, I. A Polysulfobetaine Hydrogel for Immobilization of a Glucose-Binding Protein. RSC Adv. 2016, 6, 83890–83900. [Google Scholar] [CrossRef]
- Dehmlow, E.V.; Dehmlow, S.S. Phase Transfer Catalysis, 3rd ed.; VCH: Weinheim, Germany, 1993; Chapter 1; pp. 1–28. [Google Scholar]
- Mukerjee, P.; Gumkowski, M.J.; Chan, C.C.; Sharma, R. Determination of Critical Micellization Concentrations of Perfluorocarboxylates using Ultraviolet Spectroscopy: Some Unusual Counterion Effects. J. Phys. Chem. 1990, 94, 8832–8835. [Google Scholar] [CrossRef]
- Hobley, J.; Kuge, Y.; Gorelik, S.; Kasuya, M.; Hatanaka, K.; Kajimoto, S.; Fukumura, H. Water Expansion Dynamics after Pulsed IR Laser Heating. Phys. Chem. Chem. Phys. 2008, 10, 5256–5263. [Google Scholar] [CrossRef]
- Gao, W.; Kwee, H.; Hobley, J.; Liu, T.; Phang, I.Y.; Ling, X.Y. Graphene Liquid Marbles as Photothermal Miniature Reactors for Reaction Kinetics Modulation. Angew. Chem. 2015, 127, 4065–4068. [Google Scholar] [CrossRef]
- Dong, D.C.; Winnik, M.A. The Py Scale of Solvent Polarities. Can. J. Chem. 1984, 62, 2560–2565. [Google Scholar] [CrossRef]
- Karpovich, D.S.; Blanchard, G.J. Relating the Polarity-Dependent Fluorescence Response of Pyrene to Vibronic Coupling. Achieving a Fundamental Understanding of the py Polarity Scale. J. Phys. Chem. 1995, 99, 3951–3958. [Google Scholar] [CrossRef]
- Wang, S.; Jiang, L. Definition of Superhydrophobic States. Adv. Mater. 2007, 19, 3423–3424. [Google Scholar] [CrossRef]
- Wenzel, R. Resistance of Solid Surfaces to Wetting by Water. Ind. Eng. Chem. 1936, 28, 988–994. [Google Scholar] [CrossRef]
- Lindstrom, A.B.; Strynar, M.J.; Libelo, E.L. Polyfluorinated Compounds: Past, Present, and Future. Environ. Sci. Technol. 2011, 45, 7954–7961. [Google Scholar] [CrossRef]
- Kotthoff, M.; Müller, J.; Jürling, H.; Schlummer, M.; Fiedler, D. Perfluoroalkyl and Polyfluoroalkyl Substances in Consumer Products. Environ. Sci. Pollut. Res. 2015, 22, 14546–14559. [Google Scholar] [CrossRef] [PubMed] [Green Version]
- Chang, E.T.; Adami, H.-O.; Boffetta, P.; Wedner, H.J.; Mandel, J.S. A Critical Review of Perfluorooctanoate and Perfluorooctanesulfonate Exposure and Immunological Health Conditions in Humans. Crit. Rev. Toxicol. 2016, 46, 279–331. [Google Scholar] [CrossRef] [PubMed]
- Kataria, A.; Trachtman, H.; Malaga-Dieguez, L.; Trasande, L. Association between Perfluoroalkyl Acids and Kidney Function in a Cross-Sectional Study of Adolescents. Environ. Health 2015, 14, 89. [Google Scholar] [CrossRef] [Green Version]
- Hu, X.C.; Andrews, D.Q.; Lindstrom, A.B.; Bruton, T.A.; Schaider, L.A.; Grandjean, P.; Lohmann, R.; Carignan, C.C.; Blum, A.; Balan, S.A. Detection of Poly- and Perfluoroalkyl Substances (PFASs) in U.S. Drinking Water Linked to Industrial Sites, Military Fire Training Areas, and Wastewater Treatment Plants. Environ. Sci. Technol. Lett. 2016, 3, 344–350. [Google Scholar] [CrossRef]

| Sample 1 | [MTAC] mol L−1 | [HEAA] mol L−1 | Crosslink. mol% | DSwNaCl 2 | DSw 3 | σ at Break kPa | ε at Break % |
|---|---|---|---|---|---|---|---|
| G1-1-Cl | 2 | - | 1.0 | 10.9 | 18.5 | 109.0 ± 10.6 | 40.0 ± 5.6 |
| G1-2-Cl | 2 | - | 1.5 | 5.9 | 13.1 | 424.0 ± 30.9 | 20.5 ± 3.8 |
| G1-3-Cl | 2 | - | 3.0 | 4.0 | 9.0 | 429.1 ± 28.6 | 13.5 ± 2.6 |
| G1-5-Cl | 2 | - | 4.5 | 3.0 | 6.3 | 485.0 ± 50.6 | 11.3 ± 2.2 |
| G2-1-Cl | 1 | 1 | 1.0 | 6.7 | 11.0 | 197.8 ± 16.6 | 52.9 ± 6.6 |
| G2-2-Cl | 1 | 1 | 2.0 | 4.0 | 7.9 | 420.5 ± 50.9 | 41.3 ± 3.9 |
| G2-3-Cl | 1 | 1 | 3.0 | 2.9 | 5.2 | 426.1 ± 28.1 | 28.0 ± 3.6 |
| G2-5-Cl | 1 | 1 | 4.5 | 2.1 | 4.9 | 432.7 ± 33.9 | 15.2 ± 4.2 |
| Sample Code/ Counter-Anion | CaS | DS | PFO | |||
|---|---|---|---|---|---|---|
| DSwA 1 | WR 2 % | DSwA 1 | WR 2 % | DSwA 1 | WR 2 % | |
| G1-2 | NA | NA | 0.26 | 94.3 | 0.30 | 90.4 |
| G1-3 | 1.1 | −9.3 | 0.45 | 82.5 | 0.48 | 81.5 |
| G2-1 | 1.1 | −11.2 | 0.40 | 70.9 | 0.22 | 95.2 |
| G2-2 | NA | NA | 0.32 | 91.1 | 0.32 | 92.1 |
| Sample Code | Counterion Cl | CaS | DS | PFO | ||||||||
|---|---|---|---|---|---|---|---|---|---|---|---|---|
| EWC 1 | Wtf 2 % | Wnf 3% | EWC 1 | Wtf 2 % | Wnf 3 % | EWC 1 | Wtf 2 % | Wnf 3 % | EWC 1 | Wtf 2 % | Wnf 3 % | |
| G1-1 | 96.4 | 74.7 | 21.7 | - | - | - | - | - | - | - | ||
| G1-2 | 94.0 | 73.6 | 20.4 | - | - | - | 31.7 | 7.3 | 24.5 | 34.8 | 14.7 | 20.1 |
| G1-3 | 88.2 | 64.1 | 24.0 | 88.2 | 64.9 | 23.2 | 30.3 | 12.2 | 18.1 | 32.5 | 12.4 | 20.1 |
| G1-5 | 83.8 | 59.0 | 24.8 | - | - | - | - | - | - | - | - | - |
| G2-1 | 95.5 | 77.0 | 18.5 | 97.0 | 73.6 | 23.4 | 73.3 | 59.7 | 13.6 | 45.5 | 31.8 | 13.6 |
| G2-2 | 91.2 | 66.7 | 24.5 | - | - | - | 52.8 | 32.4 | 20.4 | 45.4 | 34.1 | 18.7 |
| G2-3 | 87.9 | 66.6 | 21.3 | - | - | - | - | - | - | - | - | - |
| G2-5 | 83.8 | 62.1 | 21.7 | - | - | - | - | - | - | - | - | - |
Publisher’s Note: MDPI stays neutral with regard to jurisdictional claims in published maps and institutional affiliations. |
© 2021 by the authors. Licensee MDPI, Basel, Switzerland. This article is an open access article distributed under the terms and conditions of the Creative Commons Attribution (CC BY) license (https://creativecommons.org/licenses/by/4.0/).
Share and Cite
Danko, M.; Kronekova, Z.; Krupa, I.; Tkac, J.; Matúš, P.; Kasak, P. Exchange Counterion in Polycationic Hydrogels: Tunability of Hydrophobicity, Water State, and Floating Capability for a Floating pH Device. Gels 2021, 7, 109. https://doi.org/10.3390/gels7030109
Danko M, Kronekova Z, Krupa I, Tkac J, Matúš P, Kasak P. Exchange Counterion in Polycationic Hydrogels: Tunability of Hydrophobicity, Water State, and Floating Capability for a Floating pH Device. Gels. 2021; 7(3):109. https://doi.org/10.3390/gels7030109
Chicago/Turabian StyleDanko, Martin, Zuzana Kronekova, Igor Krupa, Jan Tkac, Peter Matúš, and Peter Kasak. 2021. "Exchange Counterion in Polycationic Hydrogels: Tunability of Hydrophobicity, Water State, and Floating Capability for a Floating pH Device" Gels 7, no. 3: 109. https://doi.org/10.3390/gels7030109
APA StyleDanko, M., Kronekova, Z., Krupa, I., Tkac, J., Matúš, P., & Kasak, P. (2021). Exchange Counterion in Polycationic Hydrogels: Tunability of Hydrophobicity, Water State, and Floating Capability for a Floating pH Device. Gels, 7(3), 109. https://doi.org/10.3390/gels7030109

